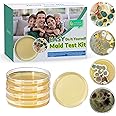
Mold Test Kit for Home - 4 Simple Detection Tests for HVAC, Surfaces & Indoor Air Quality, DIY Black Mold Detector Testing ki

| Manufacturer | Breathe Tech Ltd |
|---|---|
| Part Number | BTL40001 |
| Product Dimensions | 3.56 x 7.11 x 8.38 cm; 113.4 g |
| Batteries | 1 Lithium Ion batteries required. (included) |
| Item model number | BTL40001 |
| Colour | White |
| Style | Modern Aesthetic |
| Power Source | Corded Electric |
| Voltage | 3.7 Volts |
| Included Components | Airmonitor Plus, Charging Cable, User Guide |
| Batteries Included? | Yes |
| Batteries Required? | Yes |
| Battery Cell Type | Lithium Ion |
| Warranty Description | 2 Year Manufacturer |
| Item Weight | 113 g |
Image Unavailable
Colour:
-

-
-
- To view this video, download
BREATHE Airmonitor Plus: Smart Air Quality Monitor Indoor - 8-in-1 CO2 Meter, Formaldehyde Detector, VOC Meter, PM1/2.5/10, Temperature & Humidity - Air Quality Tester for Home with App
Purchase options and add-ons
| Brand | BREATHE |
| Style | Modern Aesthetic |
| Power source | Corded Electric |
| Colour | White |
| Product Dimensions | 3.6D x 7.1W x 8.4H Centimetres |
| Item weight | 113 g |
| Compatible devices | Android devices running v6.0 or later, iOS devices running v11.0 or later |
| Sensor type | TVOC |
| Manufacturer | Breathe Tech Ltd |
About this item
- COMPREHENSIVE INDOOR AIR QUALITY MONITORING - Monitor your home’s air with this advanced indoor air quality monitor. Measures PM1, PM2.5, PM10, CO2, TVOC, formaldehyde, temperature, and humidity for a complete home air quality test.
- HIGH-PRECISION SENSORS - Utilizes advanced laser particulate matter sensors and NDIR CO2 meters for accurate real-time air quality readings.
- SMART AIR QUALITY SENSOR WITH APP CONTROL - Stay connected with the free Breathe Tech App. This smart air quality monitor syncs via Wi-Fi, letting you track air quality in real-time, view trends, and receive alerts from anywhere—an ideal air quality tester for home.
- CO2 METER FOR HEALTHIER LIVING - Equipped with a precise CO2 meter, this air quality monitor indoor detects rising CO2 levels, helping you ventilate to boost focus, reduce drowsiness, and maintain a healthy environment—perfect for homes and offices.
- EASY CALIBRATION – Built-in quick-calibration tools ensure accurate CO₂, VOC, HCHO, and temperature readings. Clear instructions included for fast setup.
- AIR QUALITY TESTS FOR HOME MADE SIMPLE - No complex setup needed! This air quality test kit connects in under 30 seconds via the app, offering instant readings and easy-to-read graphs—an intuitive indoor air quality meter for all users.
- BOOST FOCUS & PRODUCTIVITY - Monitor air quality to prevent concentration issues caused by high CO2 or pollutants. Ideal for home offices, study spaces, or anywhere you need peak performance—outperforms basic air quality testers for homes.
- MOLD & AIR QUALITY MONITOR INDOOR MOLD SOLUTION - Detect conditions that promote mold with humidity and particulate tracking (PM1/2.5/10). A powerful air quality monitor mold detecting tool.
Frequently bought together

Videos for similar products
From the brand

-

Smarter Air, Healthier You
At Breathe Tech, we believe clean air should be accessible to all, without the complexity of big brands or the risks of unreliable imports. Since 2017, we’ve built high-performance air quality monitors with smart technology, intuitive design, and a commitment to real value.
Our mission: help you breathe better, live healthier, and take control of your air - wherever life takes you.
-
How we get our start?
Breathe Tech was founded to empower healthier lives through air quality awareness. We create high-quality, reliable air monitors for homes, schools, and workplaces.
What makes our products unique?
Airmonitor Plus offers accurate insights with premium sensors and an intuitive app. We provide trusted USA-based support and ongoing software updates driven by customer feedback.
What problem are we solving?
We help make the invisible visible—detecting PM2.5, VOCs, formaldehyde, and more—so you can improve your indoor air and protect what matters most.
-

Track Air. Take Control.
See real-time levels of CO₂, VOCs, PM2.5, and more—so you can act fast and breathe better in every space you care about.
-

Smarter Air Monitoring
Accurate, app-connected, and beautifully designed; Airmonitor Plus helps you protect your air, your family, and your peace of mind.
Product Description




-
What air quality metrics does the Airmonitor Plus measure?
It monitors 8 vital indoor air parameters: PM1.0, PM2.5, PM10 (particulates); CO₂ (via NDIR sensor); TVOC (volatile organic compounds); HCHO (formaldehyde); Temperature; and Humidity.
-
How accurate is the CO₂ sensor?
The CO₂ sensor uses a professional-grade NDIR module with ±50 ppm accuracy
-
Is the Airmonitor Plus easy to set up and use?
Absolutely:
• Connects to 2.4 GHz Wi Fi in under 30 seconds via the Breathe Tech app
• You can silence the alarm easily by pressing the rear button twice, or customize notifications in-app.
-
Can I view and export historical data?
Yes. The free Breathe Tech app stores up to 30 days of data, visible with clear graphs, and you can export it in CSV format for trend analysis.
-
How long does the battery last and what's best for continuous use?
• The built-in battery offers up to 3 hours of portable use depending on settings
• For continuous monitoring, simply plug it into a 5V power supply.
Product information
Technical Details
Additional Information
| ASIN | B0CLYRBRSB |
|---|---|
| Customer Reviews |
4.3 out of 5 stars |
| �鶹�� Rank |
|
| Date First Available | May 10 2025 |
Feedback

Product summary presents key product information
Keyboard shortcut
Shift
+
Alt
+
opt
+
D
Product Summary: BREATHE Airmonitor Plus: Smart Air Quality Monitor Indoor - 8-in-1 CO2 Meter, Formaldehyde Detector, VOC Meter, PM1/2.5/10, Temperature & Humidity - Air Quality Tester for Home with App
From BREATHE
4.3 out of 5 stars, 314 ratings
Customer reviewsAbout this Item
- COMPREHENSIVE INDOOR AIR QUALITY MONITORING - Monitor your home’s air with this advanced indoor air quality monitor. Measures PM1, PM2.5, PM10, CO2, TVOC, formaldehyde, temperature, and humidity for a complete home air quality test.
- HIGH-PRECISION SENSORS - Utilizes advanced laser particulate matter sensors and NDIR CO2 meters for accurate real-time air quality readings.
- SMART AIR QUALITY SENSOR WITH APP CONTROL - Stay connected with the free Breathe Tech App. This smart air quality monitor syncs via Wi-Fi, letting you track air quality in real-time, view trends, and receive alerts from anywhere—an ideal air quality tester for home.
- CO2 METER FOR HEALTHIER LIVING - Equipped with a precise CO2 meter, this air quality monitor indoor detects rising CO2 levels, helping you ventilate to boost focus, reduce drowsiness, and maintain a healthy environment—perfect for homes and offices.
- EASY CALIBRATION – Built-in quick-calibration tools ensure accurate CO₂, VOC, HCHO, and temperature readings. Clear instructions included for fast setup.
- AIR QUALITY TESTS FOR HOME MADE SIMPLE - No complex setup needed! This air quality test kit connects in under 30 seconds via the app, offering instant readings and easy-to-read graphs—an intuitive indoor air quality meter for all users.
- BOOST FOCUS & PRODUCTIVITY - Monitor air quality to prevent concentration issues caused by high CO2 or pollutants. Ideal for home offices, study spaces, or anywhere you need peak performance—outperforms basic air quality testers for homes.
- MOLD & AIR QUALITY MONITOR INDOOR MOLD SOLUTION - Detect conditions that promote mold with humidity and particulate tracking (PM1/2.5/10). A powerful air quality monitor mold detecting tool.
Product description
Feedback
Did you find this product summary feature useful?